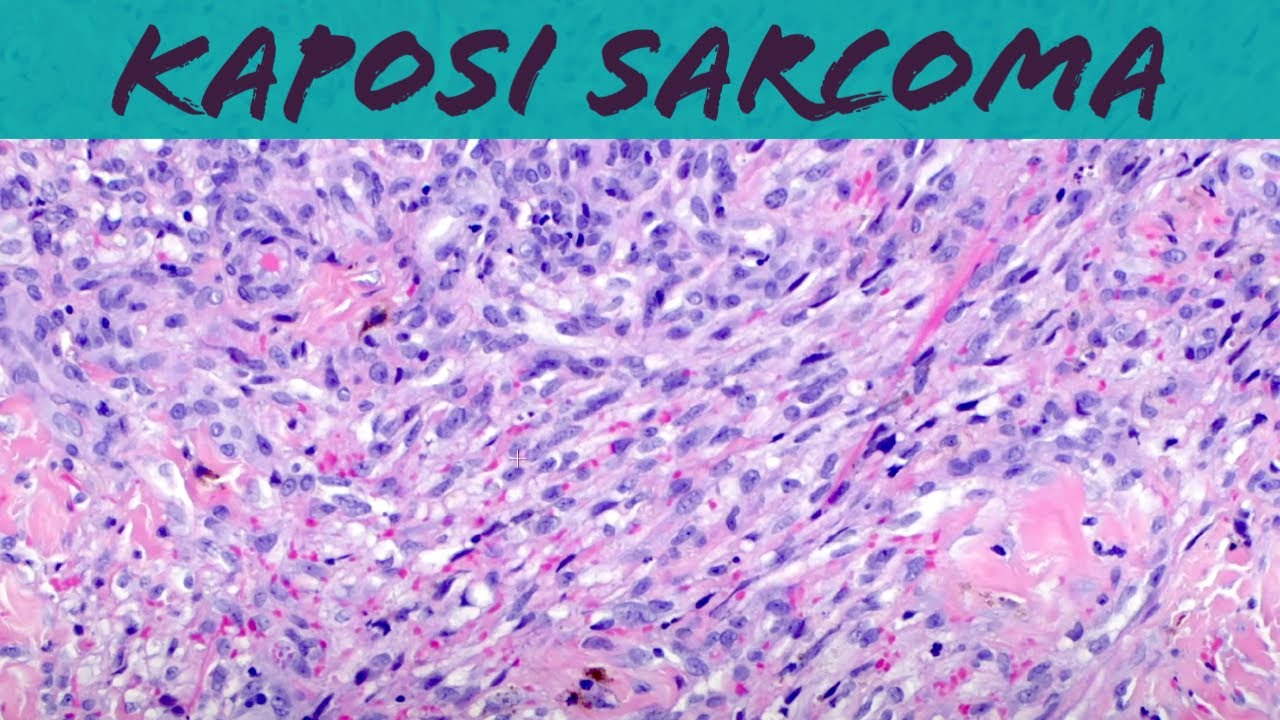
Kaposi sarcoma (vascular tumor pathology histology dermpath dermatology dermatopathology HIV AIDS)

and um uh epithelioid hemangio endothelial is uh the lung and the liver are the most common sites and in those locations there's quite a bit of morbidity and mortality many of those patients undergo organ transplant to try to control their disease it's a very serious disease to have and a subset of those patients sometimes up to 50 percent will eventually die from their disease um a minority of cases maybe 10 or so will occur in the skin and the soft tissue and in that setting they tend to be much more indolent and well-behaved than for
the organ-based eags but they may still cause mortality um some of those skin and soft tissue epithelial hemangiotheliums will metastasize and kill the patient and the other thing that's important to note is that the organ-based ehes can sometimes metastasize to the skin and mimic a primary tumor so if i ever see ehe in the skin or soft tissue i usually will point out that you know i can't exclude that this could be a metastasis and they need to scan the patient and make sure they don't have internal disease so here's an example of uh there's
not a specific appearance for this but this kind of this ill-defined nodule with some surrounding erythema um and maybe like kettification so they don't have a very specific appearance clinically and most patients don't have any idea that they have this so it's hard to find good clinical pictures of epithelioid hepatoendothelioma and here's microscopically what they look like when they're in the skin they are a dermal or subcutaneous nodule and at higher power the classic feature are epithelioid cells that are arranged in cords and chains or small nests within this kind of mixoid and sclerotic or
mucinous and sclerotic background and when you see the cells they have these vacuoles in their cytoplasm and those are referred to as blister cells and traditionally these blister cells will often have little red cell fragments within them and that's because these are actually the tumor cells are attempting to recapitulate um vascular lumen formation so these are abortive lumens forming within the cytoplasm of the tumor cell it's kind of a similar concept to what you might see in say lobular breast cancer which has those abortive little glandular structures that can have secretion inside them so those
are the classic blister cells of epithelioid hemangioenthelioma but i will point out you can have vacuoles in lots of different vascular tumors any vascular tumor with plump epithelioid appearing endothelial cells can have the tendency to have vacuole formation so just just to point that out that just because you have a blister cell does not mean for sure that something is an uh epithelioid hemangioendothelioma and another important note is that these tumors usually do not make well-formed infiltrated vascular channels like angiosarcoma would and that is um that's a useful thing to help distinguish ehe from angiosarc
and uh that's why these tumors originally when they were described in the lung people for a long time thought ehe was an unusual form of carcinoma and actually my mentor dr weiss was the first person to realize that these were vascular tumors and to name the epithelioid hemangiothelioma in 1982. so uh so these can be tricky they don't necessarily look like a vascular tumor at first glance and um they may also express cytokeratin just like epithelium angiosarc so be very careful because it's easy to see a tumor like that in the skin it's carrots and
positive it's easy to think that could be metastatic breast cancer or something like that um and so additional immunostains could really help you they're doing some vascular markers would solve the problem and more recently brian rubin at cleveland clinic and some others have described that there is a translocation in epithelial hemangio endothelioma that's the wwtr1 cam21 translocation and that's found in the majority of ehes and then a small subset will have a different translocation yap tf e3 so you can test for these uh via fish in difficult cases i actually have one right now that
that brian rubin is is doing fish on because i think it's probably an epithelial angiosarch but i just want to be sure it's not an unusual malignant epithelial hemangiothelioma because there's treatment difference for the patient so so that's a useful test in challenging cases to do fish there